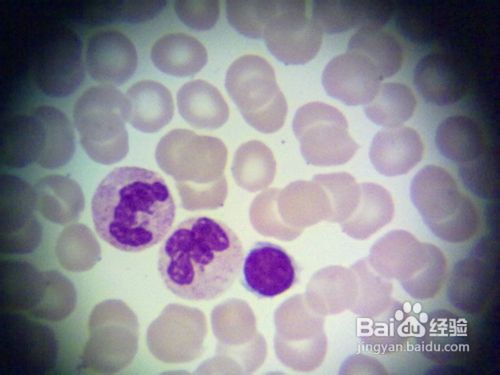
H7N9的主要症状

H7N9的主要症状
1、H7N9的一般症状为:发热,咳嗽,少痰,可伴有头痛、肌肉酸痛和全身不适。

2、重症患者的症状表现为:重症肺炎,体温大多持续在39℃以上,出现呼吸困难,可伴有咯血痰

3、再严重的h7n9的患者会快速进展出现急性呼吸窘迫综合征、纵隔气肿、脓毒症、休克、意识障碍及急性肾损伤等。

4、H7N9患者的血常规症状。白细胞总数一般不高或降低,多有白细胞总数及淋巴细胞减少,并有血小板降低。
5、H7N9患者核酸症状表现为:对患者呼吸道标本(如鼻咽分泌物、口腔含漱液、气管吸出物或呼吸道上皮细胞)采用real time PCR(或RT-PCR)检测到H7N9禽流感病毒核酸。

6、H7N9患者胸部影像学检查症状表现为:发生肺炎的患者肺内出现片状影像,呈双肺多发磨玻璃影及肺实变影像,可合并少量胸腔积液。发生ARDS时,病变分布广泛。

声明:本网站引用、摘录或转载内容仅供网站访问者交流或参考,不代表本站立场,如存在版权或非法内容,请联系站长删除,联系邮箱:site.kefu@qq.com。